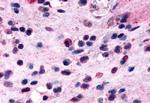
CRTH2 Antibody in Immunohistochemistry (Paraffin) (IHC (P))

Search
Invitrogen
CRTH2 Polyclonal Antibody
{{$productOrderCtrl.translations['antibody.pdp.commerceCard.promotion.promotions']}}
{{$productOrderCtrl.translations['antibody.pdp.commerceCard.promotion.viewpromo']}}
{{$productOrderCtrl.translations['antibody.pdp.commerceCard.promotion.promocode']}}: {{promo.promoCode}} {{promo.promoTitle}} {{promo.promoDescription}}. {{$productOrderCtrl.translations['antibody.pdp.commerceCard.promotion.learnmore']}}
产品信息
PA5-33721
种属反应
宿主/亚型
分类
类型
抗原
偶联物
形式
浓度
规格
纯化类型
保存液
内含物
保存条件
运输条件
RRID
产品详细信息
Percent identity with other species by BLAST analysis: Human, Gorilla, Monkey (100%) Gibbon (95%) Panda, Dog (90%) Elephant, Bovine, Horse (85%).
靶标信息
CRTH2 (GPR44) is a chemoattractant receptor-homologous molecule expressed on Th2 cells that is an identified receptor for the prostaglandin D2 (PGD2) and prostaglandin D receptor. CRTH2 is expressed on Th2 cells and eosinophils and mediates chemotaxis of these cells to PGD2 and is thus thought to be a key receptor mediating eosinophil and Th2 recruitment during allergic responses. However, CRTH2-null mice showed enhanced eosinophil recruitment into the lung consistent with observations that the CRTH2-null mice produced significantly higher amounts of interleukin-5 (IL-5) and IL-3. This suggests that CRTH2 plays a nonredundant role in restricting eosinophilia and allergic response in vivo. CRTH2 is also a novel member of the G protein-coupled leukocyte chemoattractant receptor family, which is selectively expressed in Th2 but not Th1 lineage cells. CRTH2 has been reported to be expressed in the central nervous system, peripheral tissues, and in blood cells, particularly activated T helper-2 cells. Two transcripts have been isolated: a 3.5 kb transcript expressed primarily in the thalamus, frontal cortex, pons and hippocampus; and a 3.4 kb transcript expressed in fetal liver, leukocytes and thymus. CRTH2 is selectively expressed in vivo in an activated state of Th2 cells including allergen-responsive Th2 cells, suggesting its pivotal roles in ongoing Th2-type immune reactions. At least two different isoforms of CRTH2 are known to exist. Single nucleotide polymorphisms in the 3' UTR of the CRTH2 gene have been associated with asthma susceptibility.
仅用于科研。不用于诊断过程。未经明确授权不得转售。
篇参考文献 (0)
生物信息学
蛋白别名: CD294; chemoattractant receptor homologous molecule expressed on T helper type 2 cells; Chemoattractant receptor-homologous molecule expressed on Th2 cells; CRTH2/GPR44; G-protein coupled receptor; DL1R; G-protein coupled receptor 44; MGC130436; Prostaglandin D2 receptor 2; putative G-protein coupled receptor 44; unnamed protein product
基因别名: CD294; CRTH2; DL1R; DP2; GPR44; PTGDR2
UniProt ID: (Human) Q9Y5Y4
Entrez Gene ID: (Human) 11251